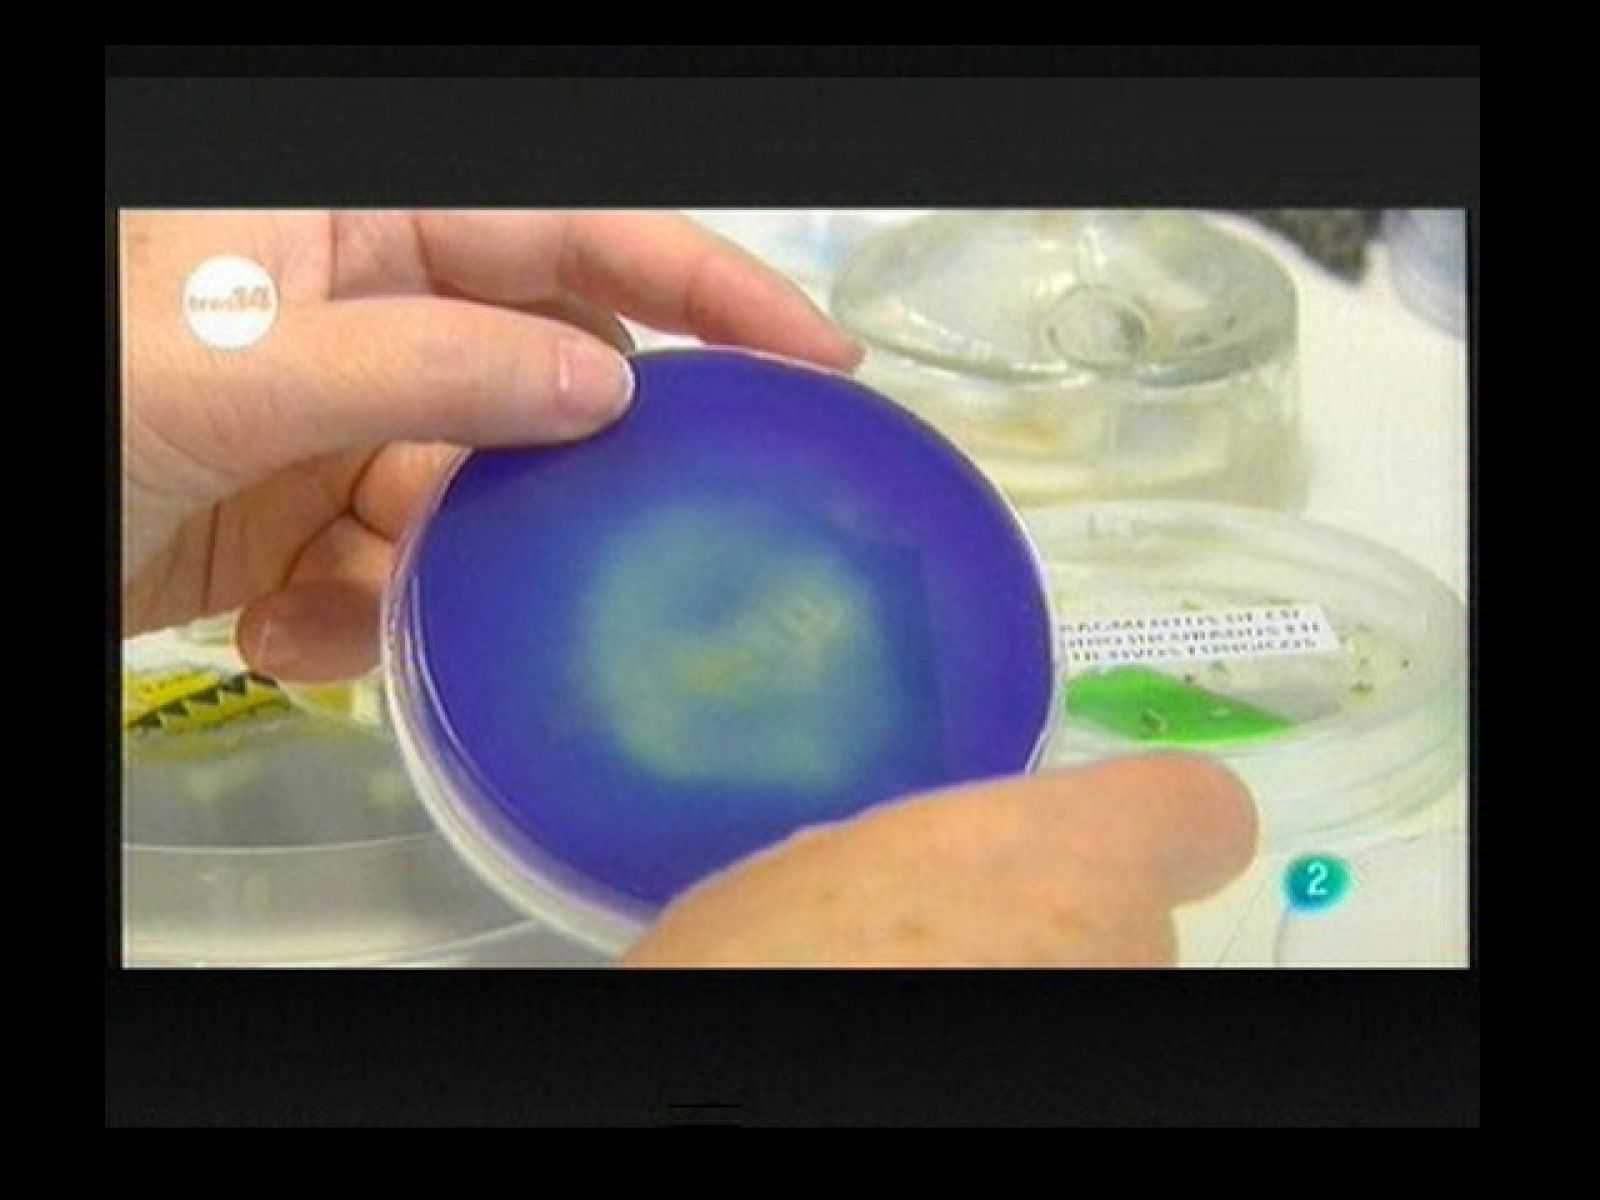
Memorias más seguras (seguridad)

tres14
Memorias más seguras
Podemos leer textos escritos en piedras milenarias pero hoy, en una sociedad en la que generamos más información que nunca, guardamos los datos en...
24/10/2010 00:04:22